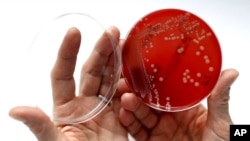

ในห้องทดลองที่ล้ำสมัยของมหาวิทยาลัยโคโลราโด้ คุณ Anushree Chatterjee สวมเเว่นตานิรภัยและถุงมือสีม่วง ขณะกำลังยื่นมือเข้าไปในกล่องควบคุมเชื้อโรคอย่างระมัดระวังเพื่อตรวจดูจานเพาะเชื้อเเบคทีเรียที่เรียกว่า "ซูเปอร์บักส์" ที่ก่อให้เกิดอาการป่วยรุนแรงจนบำบัดไม่ได้ผลด้วยยาฆ่าเชื้อโรคปกติทั่วไป
Anushree Chatterjee อธิบายว่าเชื้อเเบคทีเรียดื้อยารุนแรงเหล่านี้ ในบางกรณีดื้อต่อยาปฏิชีวนะมากกว่า 20 ชนิดด้วยกัน ทีมนักวิทยาศาสตร์ต้องใช้เวลาหลายปีในการพัฒนายาปฏิชีวนะเเบบทั่วไปที่มีส่วนประกอบจากตัวเชื้อโรค เพื่อนำมาใช้กำจัดการติดเชื้อเเบคทีเรีย
Prashant Nagpal สามีและผู้ร่วมงานของ Chatterjee กล่าวว่า นักวิทยาศาสตร์พัฒนายาปฏิชีวนะขึ้นมาไม่ทันเพื่อรับมือกับซุปเปอร์บักส์ เขาจึงคิดค้นระบบใหม่ขึ้นมาเพื่อช่วยในการพัฒนายาปฏิชีวนะชนิดใหม่ๆ ได้เร็วกว่าเชื้อโรค หรืออาจจะเร็วเท่าๆ กับความสามารถในการปรับตัวของเชื้อโรค
เพื่อให้บรรลุเป้าหมายที่ตั้งไว้นี้ ห้องทดลองของ Nagpal วิเคราะห์ดีเอ็นเอของซูเปอร์บักส์ หลังจากนั้นจะทำการพัฒนายาปฏิชีวนะขึ้นมารับมือโดยเฉพาะเจาะจงกับเชื้อโรคนั้นได้ภายในเวลาไม่กี่วัน
เขาพัฒนายาปฏิชีวนะขึ้นอย่างรวดเร็วจากการใช้เทคโนโลยี "ควอนตัมดอท" ซึ่งเป็นสารอนินทรีย์กึ่งตัวนำที่มีขนาดเล็กระดับนาโนเมตร
ควอนตัมดอทเเต่ละตัวที่ทีมนักวิจัยพัฒนาขึ้นนี้ มีขนาดเล็กกว่าเซลล์ในร่างกายคนเราถึง 20,000 เท่าตัว เมื่อนำควอนตัมดอทหลายล้านตัวมาผสมเข้าด้วยกันในน้ำ ฉายแสงอุลตราไวโอเล็ตลงไป ควอนตัมดอทที่มีขนาดต่างกันจะเรืองสีออกมาได้หลายสี ไม่ว่าจะเป็นสีส้ม สีเหลืองและสีเขียว
Nagpal กล่าวกับผู้สื่อข่าววีโอเอว่า เพื่อกำจัดซูเปอร์บักส์ชนิดใดชนิดหนึ่ง เขาจะบรรจุควอนตัมดอทลงไปในหลอดเล็กๆ เท่ากับปลอกนิ้วมือที่ช่างเย็บผ้าใช้ และหากเชื้อเเบคทีเรียดื้อยาซูเปอร์บักส์ปรับตัว ทีมนักวิจัยจะปรับควอนตัมดอทตามไปด้วย ซึ่งจะเพิ่มประสิทธิภาพในการกำจัดเชื้อโรคที่ปรับตัวอย่างได้ผล
เขากล่าวว่า สิ่งที่น่าตื่นเต้นอย่างหนึ่งของการบำบัดวิธีนี้ คือนักวิจัยสามารถปรับระดับความเเรงของควอนตัมดอทนี้ได้ ด้วยการดึงเอาอะตอมหนึ่งตัวออกจากควอนตัมดอท หรืออาจจะเติมอะตอมเข้าไปอีกหนึ่งตัว
และหากเชื้อเเบคทีเรียยังปรับตัวต่ออนุมูลอิสระเหล่านี้อีก ทีมนักวิจัยสามารถปรับควอนตัมดอทได้อีกหลายแบบ ตั้งเเต่การปรับส่วนประกอบ ขนาดหรือรูปทรงของควอนตัมดอท
เมื่อควอนตัมดอทนี้เข้าไปในร่างกายผู้ป่วย ควอนตัมดอทจะไม่ทำงานจนกระทั่งถูกกระทบด้วยเเสง นักวิจัยชี้ว่าแค่ให้ผู้ป่วยนั่งในห้องที่เปิดไฟสว่าง ก็เพียงพอเเล้วที่จะกระตุ้นให้ควอนตัมดอทเริ่มทำงานทั่วร่างกาย หรือกระตุ้นเป็นจุดๆ ตามเป้าหมายที่ต้องการก็ได้
Nagpal กล่าวว่า แพทย์สามารถให้การบำบัดแบบนี้ได้ในห้องที่ปิดไฟมืด และให้ลำแสงส่องไปใกล้กับที่ตั้งของตับ เพื่อบำบัดการอักเสบเฉพาะจุด ส่วนควอนตัมดอทที่อยู่ในจุดอื่นๆ ของร่างกายจะไม่ทำงานเพราะไม่ได้รับเเสงกระตุ้น
Nagpal กล่าวว่า เมื่อได้รับการกระตุ้นให้เริ่มทำงานด้วยเเสง ควอนตัมดอทในร่างกายคนป่วยจะส่งอนุมูลอิสระขนาดเท่ากับอะตอมที่ถูกออกแบบ และโปรแกรมให้กำจัดเชื้อเเบคทีเรียดื้อยาตัวใดตัวหนึ่งเป็นการเฉพาะ
นักวิจัยกล่าวว่า ควอนตัมดอทสร้างอาวุธขนาดเล็กหรืออนุมูลอิสระนี้ขึ้นจากออกซิเจนและน้ำ เพื่อจัดการกับเชื้อเเบคทีเรียโดยไม่เป็นอันตรายต่อเซลล์ของสัตว์เลี้ยงลูกด้วยนมหรือคนป่วย
Chatterjee ได้ทดสอบคุณภาพของควอนตัมกับหนอน roundworms ที่มักจะตายเพราะติดเชื้อเเบคทีเรียและจากการทดลอง นักวิจัยพบว่าควอนตัมดอทที่ออกแบบขึ้น ฆ่าเชื้อโรคได้โดยไม่เป็นอันตรายแก่หนอน
Chatterjee กล่าวว่า ผลการทดลองบำบัดนี้สร้างความตื่นเต้นอย่างมาก เพราะชี้ว่าวิธีการบำบัดด้วยควอนตัมดอทนี้ ช่วยกำจัดส่วนใหญ่ของเชื้อโรคดื้อยารุนแรงเหล่านี้ได้
Chatterjee กับ Nagpal ทีมนักวิจัย กล่าวว่ายังต้องใช้เวลาทดสอบอีกหลายปี ก่อนที่ควอนตัมดอทจะปลอดภัยต่อคน แต่ผลการทดลองของทีมงานทั้งหมดที่ผ่านมาสร้างความหวังเเก่ทีมงานว่าในวันหนึ่งข้างหน้าว่า อนุมูลอิสระกึ่งตัวนำขนาดจิ๋วที่พวกเขาคิดค้นขึ้นจะช่วยแพทย์รับมือกับเชื้อโรคดื้อยารุนแรงหรือซูเปอร์บักส์ได้
(รายงานโดย Shelley Schlender / เรียบเรียงโดยทักษิณา ข่ายแก้ว )